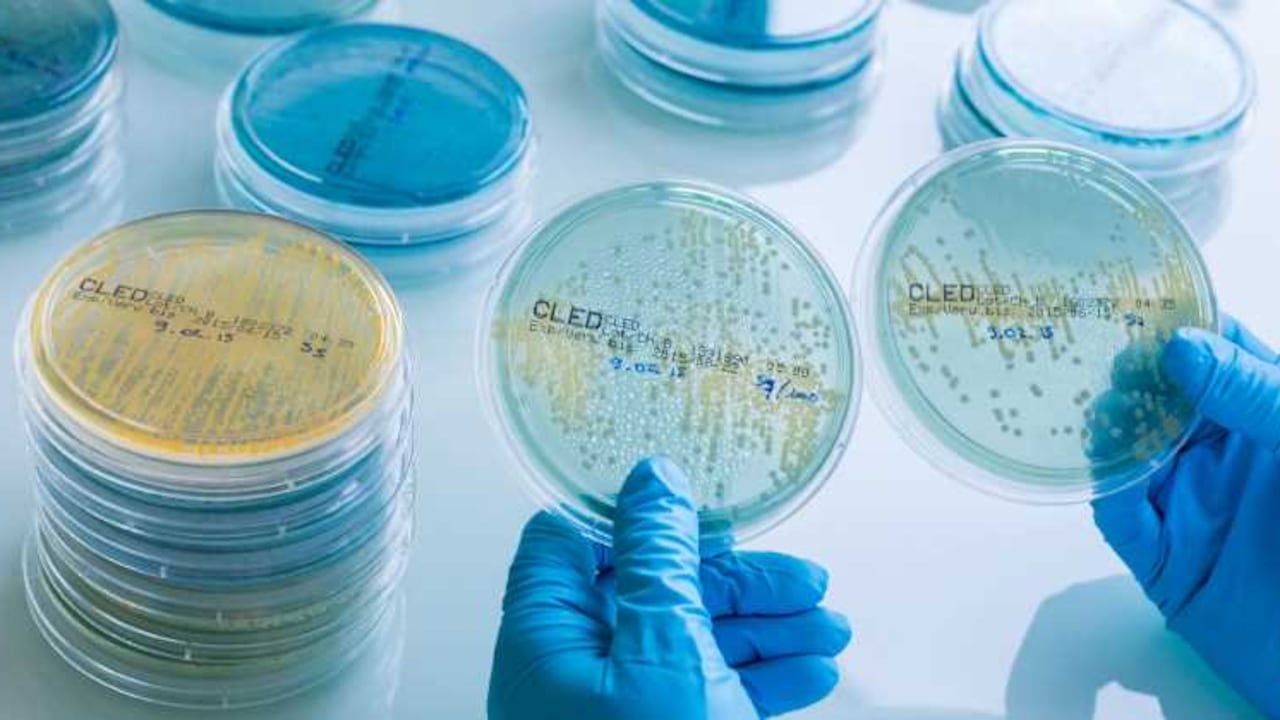

En Colombia es poco común que los investigadores se animen a hacer industria. Esta cultura, base del desarrollo económico de países como Estados Unidos, Alemania, Corea del Sur e Israel, está poco arraigada en la sociedad nacional. Incluso todavía muchos investigadores y científicos no ven con buenos ojos los lazos que se pueden establecer entre la academia y la industria.
Aun así, desde hace un par de décadas algunos científicos colombianos han abandonado los prejuicios y se han arriesgado a crear industrias basadas en el conocimiento y la innovación. Este es el caso de Soluciones Microbianas del Trópico (SMT), una empresa caldense que hace unas semanas obtuvo el primer puesto en Innova100K, un concurso organizado por el programa Alianzas para la Innovación de Colciencias que premia a empresarios innovadores colombianos.
SMT recibió el galardón gracias a que creó un insecticida innovador compuesto por tres hongos para combatir la Diaphorina citri, una mosca que en su aparato bucal tiene una bacteria que ataca los cultivos cítricos y se está convirtiendo en una plaga mundial. Ahora con los recursos y la asesoría de Colciencias, esta empresa financiará las pruebas en campo para validar la eficacia del insecticida y así obtener el certificado del Instituto Colombiano Agropecuario (ICA) para poder comercializarlo.
El premio recibido por esta empresa, radicada en Chinchiná, Caldas, no solo la retribuye por crear un producto innovador, sino reconoce a dos científicas que hace 16 años se arriesgaron a utilizar su conocimiento para crear una empresa de alto valor agregado. La historia de esta aventura comenzó en el año 2000, cuando las bacteriólogas Patricia Eugenia Vélez y María Nancy Estrada abandonaron su cómodo trabajo en el Centro Nacional de Investigaciones de Café (Cenicafé). Durante varios años habían participado en los estudios sobre el empleo de agentes biológicos para combatir las enfermedades en los cultivos del grano. “En los 14 años en Cenicafé, mi socia y yo nos especializamos en usar microorganismos benéficos para controlar plagas”, explica Vélez, quien tiene una maestría en tecnología aplicada en hongos de la Universidad de Kent, en Inglaterra.
La idea de independizarse y crear una empresa comenzó a rondarle la cabeza a Patricia luego de un viaje a Hong Kong. Además de realizar un curso en tecnologías de biotransformación, conoció los pormenores del cultivo de hongos, negocio que la apasionó. De regreso a Colombia, después de un tiempo de madurar la idea, Patricia y María renunciaron a Cenicafé y fundaron Hongos del Trópico, con el fin de cultivar y comercializar hongos comestibles.
“Sin embargo, nuestro optimismo se vino a pique cuando nos dimos cuenta de que comercializar hongos distintos al champiñón no era fácil: cultivarlos era bastante costoso y el mercado estaba reducido a la clase media y alta”, continúa Vélez. Ante estas dificultades, ambas bacteriólogas concluyeron que el conocimiento que habían acumulado en Cenicafé debería servir de base para su empresa.
Con poco capital, Patricia y María alquilaron parte de las antiguas instalaciones de Cenicafé y allí montaron su planta de producción. Desde ese momento se han dedicado a crear productos basados en microorganismos para el control de insectos y enfermedades en varios tipos de cultivos. En la actualidad esta pyme tiene cinco insecticidas registrados para su venta en el ICA y siete en proceso de aprobación.
El éxito de ambas bacteriólogas se debe a que han considerado que el vínculo entre academia e industria debe ser fuerte y la base para crear productos innovadores con un alto componente científico y tecnológico. “A pesar de ser empresaria, nunca he dejado de ser investigadora. Sigo dando clases y en la empresa recibimos a estudiantes de pregrado para que nos colaboren y realicen sus trabajos de grado, y a la fecha hemos dirigido 25 tesis. Todo esto demuestra que el emprendimiento debe ir de la mano con la ciencia”, afirma Patricia.
Junto a SMT, Innova100K premió a Frios Frutos de los Ríos, de Quibdó; Match Overseas, de Barranquilla; Mundo Panela el Trébol, de Guaduas, Cundinamarca; Mpl Aviation, de Rionegro; y Zumotec de Bucaramanga. Cinco empresas que muestran que la innovación se encuentra en todos los rincones del país.
CIENCIA
Ciencia e industria: la unión perfecta
Soluciones Microbianas del Trópico, empresa ganadora del premio Innova100K, concurso organizado por Colciencias que promueve la innovación empresarial, muestra que la academia y el emprendimiento pueden combinarse para crear industrias.
Siga las noticias de SEMANA en Google Discover y manténgase informado
9 de septiembre de 2016 a las 7:00 p. m.